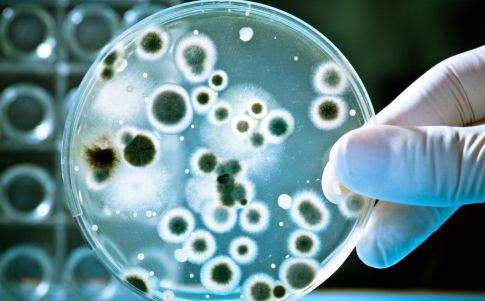
Aparecen microbios desconocidos en la Estación Espacial

Aparecen microbios desconocidos en la Estación Espacial
Cuatro nuevas bacterias han sido secuenciadas a cientos de kilómetros de la Tierra y los científicos no conocen nada de tres de ellas.
Que nadie ponga en duda la existencia de vida extraterrestre. Aunque de tipo microscópico, cuatro bacterias han sido aisladas en la ISS (acrónimo en inglés de Estación Espacial Internacional).
Según un estudio publicado en la revista Frontiers in Microbiology por científicos de Estados Unidos y la India, en colaboración con la NASA, las cuatro cepas bacterianas viven en diferentes partes de la nave. Una se encontró en un panel superior de la estación de investigación; la segunda en la cúpula; la tercera en la superficie de la mesa del comedor y la cuarta en un viejo filtro de aire HEPA que fue devuelto a la Tierra en el año 2011.
Aunque la NASA implementa gran variedad de medidas para minimizar la contaminación biológica en las naves espaciales la limpieza al 100% no puede garantizarse y los microorganismos terrestres podrían comprometer misiones de detección de vida al proporcionar falsos resultados positivos. ¿Podríamos estar ante un caso de este tipo?
Sólo una de las bacterias ha sido identificada como Methylorubrum rhodesianum, las otras tres no habían sido descubiertas previamente. Según el estudio, "el género Methylobacterium consta de 45 especies reconocidas, que están presentes de manera ubicua en una amplia variedad de hábitats, incluidos el aire, el suelo, el agua dulce y los sedimentos, y pueden existir en forma libre o asociadas con tejidos vegetales". ¿Cómo llegaron entonces al espacio?
Es probable que llegaran a la ISS como resultado de que los astronautas cultivan vegetales allí
Pero, al secuenciar las otras tres, los expertos advirtieron que todas pertenecían a una nueva especie, aunque el análisis genético reveló que estaban estrechamente relacionadas con Methylobacterium indicum. ¿Pudo evolucionar una bacteria terrestre en el espacio o se trata de especies extraterrestres?
Los microbios son compañeros incansables de los seres humanos. Hasta ahora, se han recolectado alrededor de 1.000 muestras a bordo de la estación espacial, que aún no se han devuelto a la Tierra para su posterior análisis a la espera de una futura recuperación.
Los científicos han bautizado las nuevas cepas bacterianas como IF7SW-B2T, IIF1SW-B5 e IIF4SW-B5, en honor a Ajmal Khan, un reconocido investigador indio de la biodiversidad.
Una de las cepas recién descubiertas en particular, identificada como IF7SW-B2 T, parece poseer una propensión genética a la producción de citoquinina, que ayuda en varios aspectos de la división celular vegetal. Estos microorganismos intervienen en la fijación del nitrógeno, el crecimiento de las plantas y pueden ayudar a detener los patógenos en la vegetación.
Los astronautas que viven en la estación llevan años cultivando pequeñas cantidades de alimentos, por lo que no es de extrañar que hayan aparecido microbios relacionados con las plantas a bordo de la ISS. Microbios extraterrestres porque han nacido y se han desarrollado fuera de la Tierra, ¿o no?











Comentarios
Nos interesa tu opinión